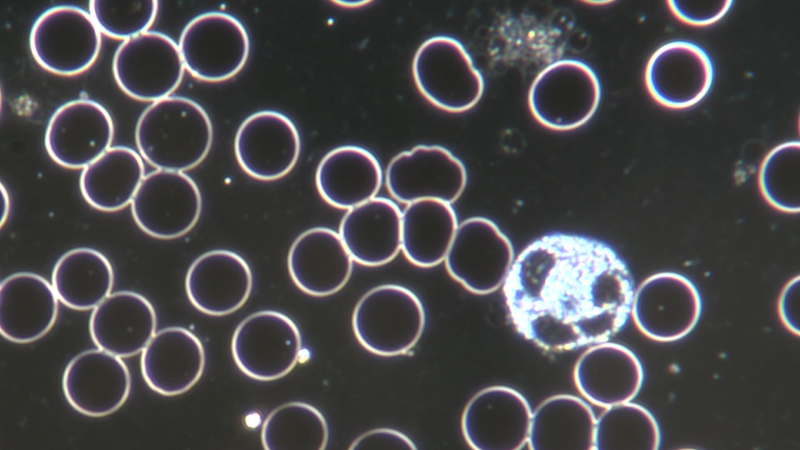
Duinkelfeld Aufnahme 1000 fache Vergrößerung

Dunkelfeld-Vitalblutanalyse im Mikroskop
Die Dunkelfeld-Mikroskopie wird oft auch als Vitalblut-Untersuchung bezeichnet.
Dies ist eine Methode, bei der man die Blutzellen, im Gegensatz zur gängigen Blutuntersuchung, im noch lebenden Zustand betrachtet und bewertet.
Bei einer herkömmlichen Blutuntersuchung wird das Blut mit Chemikalien behandelt, anschließend gefärbt und getrocknet. Es lassen sich dann viele Merkmale des "lebende " Blutes nicht mehr untersuchen.
Die Blutentnahme ( nur 1 Tropfen ! ) erfolgt nahezu schmerzfrei aus der Fingerbeere durch den Klienten selbst mittels handelsüblicher Einmal-Lanzette (wie bei einer Blutzuckermessung).
Eine Vitalblut-Untersuchung sollte stets nüchtern erfolgen, am besten also morgens oder vormittags.
Meine Ausbildung und mein Zertifikat erhielt ich bei der erfahrenen Dunkelfeld-Praktikerin Ulrike Icha.
Bei Interesse dieser etwas "anderen" Blutuntersuchung nehmen Sie bitte mit mir Kontakt auf.
Gerne kann auch die Dunkelfeldmikroskopie mit einer Bioresonanz- behandlung kombiniert werden ! In diesem Fall kann ich Ihnen ein vergünstigtes Kombi-Paket anbieten. Sprechen Sie mich bei Interesse darauf an !
Im Bild rechts sind unter anderem Erythrozyten sowie ein Leukozyt zu sehen.
Die geeigneten Therapie-Präparate erhalten Sie z.B. in unserer Partnerapotheke, der St. Nikolaus-Apotheke in 1060 Wien, bzw. sind diese in anderen Apotheken bestellbar.
Ein modernes Dunkelfeldmikroskop mit hochwertiger Optik und hochauflösender HDMI-Kamera (Abb. oben) ermöglicht faszinierende Einblicke in den Mikrokosmos des lebenden Blutes (Abb. unten).
Bei mir erfahren Sie, wie Sie Ihr Blut wieder mit positiver Energie versorgen und energetische Belastungen abbauen können.